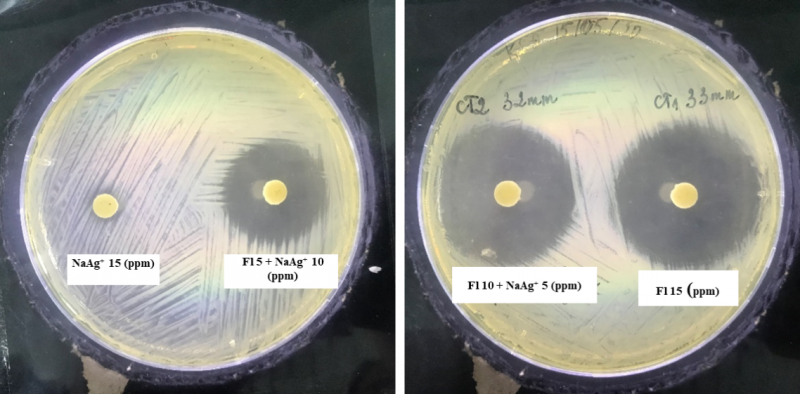

Cá Nheo mỹ là một loài cá có giá trị dinh dưỡng cao, thịt thơm ngon, bổ dưỡng. Đặc biệt, loài này có thể chủ động trong sản xuất giống và nuôi thương phẩm dưới nhiều hình thức như nuôi ghép, nuôi lồng hay nuôi trong các hệ thống ao đất. Cá có giá trị cao hơn so với các loài cá truyền thống khác nên được người nuôi lựa chọn để tăng thu nhập và phát triển kinh tế. Sau nhiều năm, phong trào nuôi cá phát triển nhanh chóng, diện tích nuôi ngày càng được mở rộng, tuy nhiên mặt trái là dịch bệnh phát sinh nhiều và diễn biến phức tạp và gây thiệt hại đáng kể cho người nuôi.

A-B: Xuất huyết mắt, gốc vây, hậu môn; C-D: xuất huyết nội quan
Triệu chứng và bệnh tích ở cá Nheo mỹ chết do A.veronii
Việc sử dụng các loại vắc xin còn gặp nhiều khó khăn khi áp dụng với các hệ thống nuôi tại Việt Nam, do vậy cho đến nay kháng sinh vẫn được dùng phổ biến để điều trị các bệnh nhiễm khuẩn ở động vật thuỷ sản. Florfenicol là một trong những kháng sinh có tác dụng tốt nhất trong việc điều trị các bệnh nhiễm khuẩn do Aeromonas spp. gây ra. Tuy nhiên, sản phẩm thuỷ sản lại là một trong những mặt hàng xuất khẩu quan trọng của nước ta, một trong những tiêu chí bắt buộc với sản phẩm là không tồn dư kháng sinh trong sản phẩm. Do vậy, cần tìm ra một lựa chọn thay thế hoặc kết hợp làm giảm liều lượng kháng sinh mà vẫn đảm bảo hiệu quả điều trị là một trong những quan tâm hàng đầu. Gần đây, công nghệ nano đang có bước phát triển mạnh mẽ với nhiều ứng dụng trong nuôi trồng thuỷ sản như nghiên cứu chẩn đoán bệnh, sản xuất vắc xin, thức ăn… Đặc biệt, ứng dụng tiềm năng của công nghệ nano trong hệ vận chuyển thuốc thông minh làm tăng thời gian tồn tại của thuốc trong cơ thể động vật thuỷ sản, chống lại sự phân huỷ của thuốc bởi enzym trong đường ruột, giảm thiểu phân rã của thuốc trong môi trường nước, giảm hàm lượng kháng sinh nhưng vẫn đảm bảo hiệu quả khi sử dụng thuốc.
Việc tìm ra phương pháp điều trị mang lại hiệu quả tốt nhất và bền vững trong tương lai đặc biệt đối với các loài cá nuôi có giá trị kinh tế hiện nay là điều vô cùng cần thiết. Chính vì vậy, nhóm tác giả thuộc khoa Thủy sản – Học viện Nông nghiệp Việt Nam đã tiến hành thử nghiệm kết hợp Nano bạc và Florfenicol trong điều trị bệnh do vi khuẩn Aeromonas veronii trên cá Nheo mỹ ở quy mô phòng thí nghiệm để làm cơ sở ứng dụng vào thực tiễn điều trị bệnh ở đối tượng nuôi này.
Kháng sinh đồ Florfenicol và Nano bạc
Qua nghiên cứu cho thấy, kháng sinh florfenicol có tác dụng diệt khuẩn rất tốt với A. veronii, đường kính vòng vô khuẩn lớn (33 mm). Tuy kết quả so sánh sự sai khác về đường kính vòng vô khuẩn trung bình cho thấy đã có sự sai khác có ý nghĩa (p<0,05) khi so sánh giữa nghiệm thức, nhưng sự kết hợp kháng sinh với nano bạc đều có khả năng diệt khuẩn khá cao. Cụ thể, nếu vòng vô khuẩn đạt 33 ± 0,5 mm khi sử dụng nồng độ 15 ppm Florfenicol thì vòng vô khuẩn chỉ giảm xuống 31,8 ± 0,76 mm khi dùng kết hợp 10 ppm florfenicol + 5 ppm nano bạc và 25,3 ± 0,57 mm khi kết hợp 5 ppm Florfenicol + 10ppm Nano bạc. Điều này chứng tỏ khi kết hợp kháng sinh florfenicol 10ppm và nano bạc 5ppm có tác dụng diệt khuẩn tốt và đảm bảo kết quả về mực độ nhạy để điều trị như khi sử dụng kháng sinh đơn thông thường (>18mm). Khi chỉ sử dụng nano bạc khả năng diệt khuẩn chỉ xuất hiện trong thời gian 4 giờ đầu (vòng vô khuẩn đạt 12 mm), sau 24 giờ Nano bạc mất tác dụng, không thấy xuất hiện vòng vô khuẩn. Điều này có thể được giải thích rằng do nano bạc hoạt động theo cơ chế ion hoá nên giai đoạn này vi khuẩn bị ức chế do tác dụng của các ion bạc được giải phóng từ hạt nano bạc. Tuy nhiên cấu trúc tế bào của vi khuẩn vẫn chưa bị phá huỷ do chưa đủ lượng, nên lúc hết ion bạc vi khuẩn lại phát triển bình thường.
Thông tin chi tiết truy cập tại :
http://tapchi.vnua.edu.vn/wp-content/uploads/2022/03/tap-chi-so-4.7.pdf
Đào Hương – NXB Học viện

